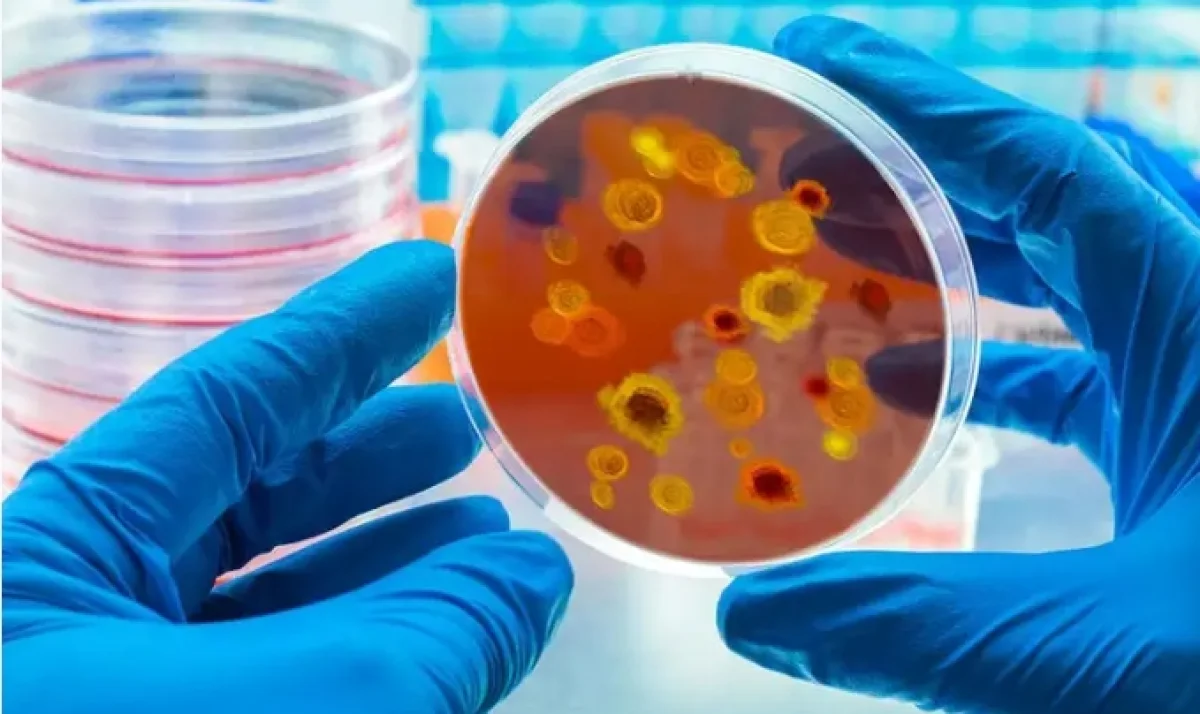

"Болезнь X", которая может по количеству смертей в 20 раз превзойти пандемию коронавируса, планируют обсудить на Всемирном экономическом форуме в Давосе с 15 по 19 января, сообщает Zakon.kz.
По информации, опубликованной на сайте
ВЭФ, обсуждение запланировано на 17 января.
В нем примут участие глава ВОЗ Тедрос Гебрейесус, министр здравоохранения Бразилии Низия Триндаде и другие специалисты.
"Болезнь X" – это абстрактное заболевание, которое потенциально способно вызвать эпидемию международного масштаба. Считается, что такую эпидемию, вероятнее всего, вызовет неизвестный человечеству патоген.
В 2018 году ВОЗ включила "болезнь Х" в список приоритетных заболеваний, чтобы ускорить исследования патогена, который, потенциально, может привести к новой пандемии. По словам главы Национального института аллергии и инфекционных заболеваний США Энтони Фаучи, "Х" в названии означает "неожиданность". В 2020 году ВОЗ заявляла, что первым "патогеном Х" с полным основанием следует признать коронавирус SARS-CoV-2, вызвавший пандемию COVID-19. Однако, по мнению специалистов, велика вероятность, что за ним последуют и другие.
В работе Давосского форума примет участие министр национальной экономики Казахстана Алибек Куантаров. Он выступит на сессии "Новый рассвет для Евразии?".
Подпишись на наш канал в Telegram
– быстро, бесплатно и без рекламы
Подписаться

Комментарии
0 комментарий(ев)